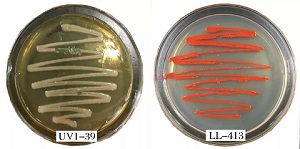
width=303,height=151,dpi=110 3

ta-name="关键词" style="margin: 0.5em 0em; padding: 10px 0px; outline: 0px; max-width: 100%; clear: both; min-height: 1em; color: rgb(51, 51, 51); font-family: -apple-system, BlinkMacSystemFont, "Helvetica Neue", "PingFang SC", "Hiragino Sans GB", "Microsoft YaHei UI", "Microsoft YaHei", Arial, sans-serif; letter-spacing: 0.544px; text-align: justify; text-indent: 0px; font-size: 16px; line-height: 1.8em; box-sizing: border-box !important; overflow-wrap: break-word !important;">ta-name="关键词.标题" style="margin: 0px; padding: 0px; outline: 0px; max-width: 100%; box-sizing: border-box !important; overflow-wrap: break-word !important; font-weight: bold !important;">关键词 舍雷肽酶;粘质沙雷氏菌;诱变育种;紫外线;微波
舍雷肽酶(serrapeptase,serratiopeptidase或serralysin),又称沙雷肽酶、沙雷蛋白酶等,是一种碱性蛋白水解酶。该酶最初是从肠杆菌粘质沙雷氏菌(Serratia marcescens)E15中分离出的一种胞外酶[1-3],因其强大的抗炎活性,被人们称之为“奇迹之酶”。舍雷肽酶具有良好的抗炎、抗肿胀、促进痰液、脓液溶解与排泄以及镇痛作用,临床用于手术后及外伤的消炎、副鼻窦炎、乳汁潴留性乳腺炎、膀胱炎、附睾炎、智齿周围炎及牙槽脓肿时的消炎,以及治疗支气管炎、肺结核、支气管哮喘时痰液不易咳出等[4-5]。早在19世纪70年代就在日本上市,随后在欧洲、亚洲等多个国家上市[6],因出色的功效和无副作用,近年来,该酶作为辅助药物和保健食品市场需求旺盛。
舍雷肽酶主要由粘质沙雷氏菌发酵生产,目前主要生产国家是日本和印度,国内虽有一些企业在销售舍雷肽酶,但并非采用粘质沙雷氏菌发酵,而是采用枯草芽孢杆菌发酵,严格来说,此类产品不能称为舍雷肽酶。李靓[7]已从家蚕肠道中分离获得1株产舍雷肽酶的粘质沙雷氏菌,在优化的发酵条件下,酶活单位达到1 000 U/mL以上,但随着菌种的传代使用,产酶活力逐渐下降至500 U/mL左右。为了提高和稳定该菌株的产酶能力,实验采用紫外线和微波对该菌株进行连续诱变,筛选高产且传代稳定的舍雷肽酶突变菌株。
1 材料与方法
1.1 材料与仪器
1.1.1 菌种
粘质沙雷氏菌(Serratia marcescens)LL-413菌株,从家蚕(Bombyx mori)肠道内分离,保藏于中国典型培养物保藏中心,保藏编号CCTCC M2015780。
1.1.2 试剂与仪器
酪蛋白:生物试剂,百奥莱生物试品有限公司;酪氨酸:生物试剂,生工生物工程(上海)股份有限公司;福林酚试剂:分析纯,上海沪试化工有限公司;以及其他普通分析纯试剂或生物试剂。
紫外-可见分光光度计(UV2600型),尤尼柯(上海)仪器有限公司;立式压力蒸汽灭菌器(LS-B50L型),上海华线医用核子仪器有限公司;生化培养箱(SPX-250B型),上海博迅实业有限公司;恒温培养摇床(HWY-2112型),上海智城分析仪器制造有限公司;微波炉(G8023CTL-K3型),中山格兰仕家用电器有限公司。
1.1.3 培养基
平板培养基(g/L):麦芽浸粉12.2,牛肉膏6.6,酵母浸出粉11.0,NaCl 5.0,MgSO4·7H2O 1.0,琼脂20.0,pH 8.0,121 ℃高压蒸汽灭菌20 min。种子和产酶培养基除不加琼脂外,其他成分同平板培养基,250 mL三角瓶装50 mL种子或产酶培养基,8层纱布扎口,121 ℃蒸汽灭菌20 min。
1.2 方法
1.2.1 酶活的测定
采用Folin-酚法测定舍雷肽酶的活力[8]。发酵液离心后,上清液经过适当倍数稀释后待测,取1 mL酶液和1 mL酪蛋白溶液(20 g/L,pH 8.0的Tris-HCl缓冲液配制)于试管中,充分混合后于37 ℃水浴中保温10 min,再加入2 mL的三氯乙酸(TCA,0.4 mol/L)终止反应,继续水浴保温20 min,经8 000×g离心5 min。取1 mL上清液,加入5 mL的Na2CO3(0.4 mol/L)和1 mL福林酚试剂,37 ℃水浴保温显色30 min,以TCA灭活的酶液相同处理为参比,测定A660,依据酪氨酸浓度-A660标准曲线计算出酶解液中酪氨酸浓度,再按舍雷肽酶的活力定义计算发酵液中舍雷肽酶的活力。舍雷肽酶活力的定义:在37 ℃反应条件下,1 min水解质量浓度为20 g/L的酪蛋白产生1 μg酪氨酸的所需的酶量(mL)为1个酶活力单位(U/mL)。
1.2.2 菌种诱变
菌悬液的制备:取培养至对数生长期(16 h)的培养液1 mL,离心收集菌体,加入等量无菌生理盐水重悬菌体,再次离心收集菌体,重复2次。用100 mL无菌生理盐水重悬菌体于三角瓶中,加入1根无菌回形针于磁力搅拌器上搅拌20 min后备用。
紫外线诱变[9]:直径9 cm无菌培养皿7副,分别加入制备好的菌悬液2 mL。打开培养皿盖,在距离15 W紫外灯30 cm处边搅拌边照射,分别照射0、40、60、80、100、120、140 s。完毕后将各菌液用生理盐水稀释至103~105倍,取0.1 mL稀释菌液涂布平板,平板黑布包裹于30 ℃下培养24 h。
微波诱变[10]:微波炉高火预热和杀菌消毒5 min,5 mL菌悬液于试管中,试管于冰水浴中,在微波炉800 W的功率下处理0、40、60、80、100、120、140 s。完毕后将各菌液用生理盐水稀释103~105倍,取0.1 mL稀释菌液涂布平板,于30 ℃培养24 h。
1.2.3 菌株的初筛与复筛
初筛:选取致死率90%以上的平板,挑取菌落转接平板培养24 h后,挑取菌体接种产酶培养基(不做重复样),30 ℃、200 r/min培养24 h,发酵液4 ℃、8 000×g离心5 min,测定上清液舍雷肽酶活力。
复筛:接种初筛获得的菌株菌体至种子培养基中,30℃、200 r/min培养24 h后,按5%的体积比接入产酶培养基,30 ℃、200 r/min培养24 h后测定舍雷肽酶的活力,每个菌株做3个重复。
1.2.4 传代稳定性试验
将诱变后的菌株以及原始菌株LL-413在平板培养基上传代培养,每代菌体都经过种子扩培和产酶培养(3个重复),测定产酶活力,传代4次。
2 结果与分析
2.1 紫外线诱变
2.1.1 紫外线诱变的致死率
测定粘质沙雷氏菌在30 ℃、180 r/min条件下的生长曲线,培养16 h进入对数生长的中期,制备的菌体经不同时长的紫外线照射,测得紫外线诱变的致死率见图1。

图1 紫外线照射对粘质沙雷氏的致死率
Fig.1 Fatality rate of Serratia marcescens irradiated by UV
由图1可以看出,随着紫外线照射时间的延长,致死率逐渐增加,当照射100 s时,致死率91.4%。一般认为致死率在90%~99.9%时,诱变效果较好[11],所以从紫外线照射时长100 s以上诱变后的平板中挑取突变株。
2.1.2 紫外线诱变菌种的筛选
从紫外线照射时长100 s以上诱变后的平板中挑取突变株50株,诱变菌株产酶培养24 h后测定舍雷肽酶活力,从中选取酶活提高30%的10个突变菌株进行复筛,复筛的10个菌株产舍雷肽酶的活性见表1。
表1 紫外线诱变突变菌种的复筛产酶活力
Table 1 Serrapeptase activity of the strains after the 1st UV mutation in re-screening

经过复筛后,UV1-26、UV1-37和UV1-39菌株的产酶活力提高幅度较大,且均达到了极显著差异水平(p<0.01),其中UV1-39突变菌株不产灵菌红素,菌落呈乳白色(图2)。不产灵菌红素菌株发酵生产舍雷肽酶,有利于提高酶产品的外观品质,在筛选产酶活力提高的前提下,优先选择此类突变株。
图2 UV1-39株紫外诱变菌株和出发菌株LL-413菌落形态
Fig.2 colony morphology of strain UV1-39 and strain LL-413
2.1.3 二次紫外线诱变菌株的筛选
对复筛后的3株菌株再次用紫外线照射100 s,诱变后UV1-39为出发菌株长出的菌落均不产灵菌红素,UV1-26和UV1-37为出发菌株长出的菌落也有少数不产灵菌红素。从UV1-39平板中挑取了18株不产灵菌红素的突变菌株,产酶培养24 h后检测舍雷肽酶活力。从中选取产酶活力提高15%的6个突变菌株进行复筛,复筛的6个菌株产舍雷肽酶活力见表2。
表2 二次紫外线诱变突变菌种的复筛产酶活力
Table 2 Serrapeptase activity of the strains after the 2nd UV mutation in re-screening

从表2可知,UV2-6产酶活力提高幅度较大,且达到了极显著差异水平(p<0.01),较其出发菌株UV1-39提高了18.1%,较原始出发菌株LL-413提高了37.9%,该菌株不产灵菌红素,所以选其作为进一步微波诱变的出发菌株。
2.2 微波诱变
2.2.1 微波诱变的致死率
以UV2-6为出发菌株,在设定微波功率为800 W的条件下,采用不同时长的微波辐射,测定微波诱变对粘质沙雷氏菌的致死率,结果见图3。

图3 微波辐射对粘质沙雷氏的致死率
Fig.3 Fatality rate of Serratia marcescens irradiated by microwave
随着微波辐射时间的增加,菌体死亡率不断的提高。辐射100 s时致死率为90.8%,所以从微波辐射时长100 s以上诱变后的平板中挑取突变株。
2.2.2 微波诱变突变菌种的筛选
从微波辐射时长100 s以上诱变后的平板中挑取突变株30株,摇瓶产酶培养24 h,测定各菌株产舍雷肽酶的活力,选取了产酶活力提高30%的10个菌株进行复筛,复筛的10个菌株产舍雷肽酶的活力见表3。可以看出,多数菌株产酶活力提高的幅度较大,且均达到了极显著差异水平(p<0.01)。产酶活力提高30%的菌株有7株,说明微波对粘质沙雷氏菌诱变提高舍雷肽酶的效果非常显著。
表3 微波诱变突变菌种的复筛产酶活力
Table 3 Serrapeptase activity of the strains after micro-wave mutation in re-screening

2.3 突变菌株的传代稳定性
将经微波诱变后的MW-4,MW-6,MW-7,MW-9,MW-11,MW-14,MW-21,与原始菌株LL-413一起在平板上划线培养,传代4次,且每代均做3个重复的摇瓶产酶培养,检测舍雷肽酶活力,结果见表4。
从表4以看出,原始菌株LL-413稳定性较好,产舍雷肽酶活力稳定;MW-4、MW-6、MW-11和MW-21菌株所产舍雷肽酶活力逐代下降;MW-9和MW-14两个突变菌株产酶活力稳定,分别为982 U/mL和956 U/mL,是原始菌株LL-413的1.98倍和1.92倍。
表4 突变菌株产舍雷肽酶活性的传代稳定性
Table 4 Hereditary stability of the mutant strains for producing serrapeptase

3 结论
从家蚕肠道中分离的原始菌株粘质沙雷氏菌LL-413,经紫外线和微波连续诱变后,筛选到2株产舍雷肽酶活力提高较大的突变株MW-9和MW-14,摇瓶发酵产酶活力分别为982 U/mL和956 U/mL,分别是原始菌株LL-413的1.98倍和1.92倍。目前,国内未见关于利用粘质沙雷氏菌产舍雷肽酶的研究报道;国外研究中,由粘质沙雷氏菌产舍雷肽酶活力最高报道是2 155 U/mL[12]。
此外,突变菌株MW-9和MW-14在30℃下培养均不产灵菌红素,发酵液不再是暗红色,这一特性有利于改善成品舍雷肽酶的外观颜色。



